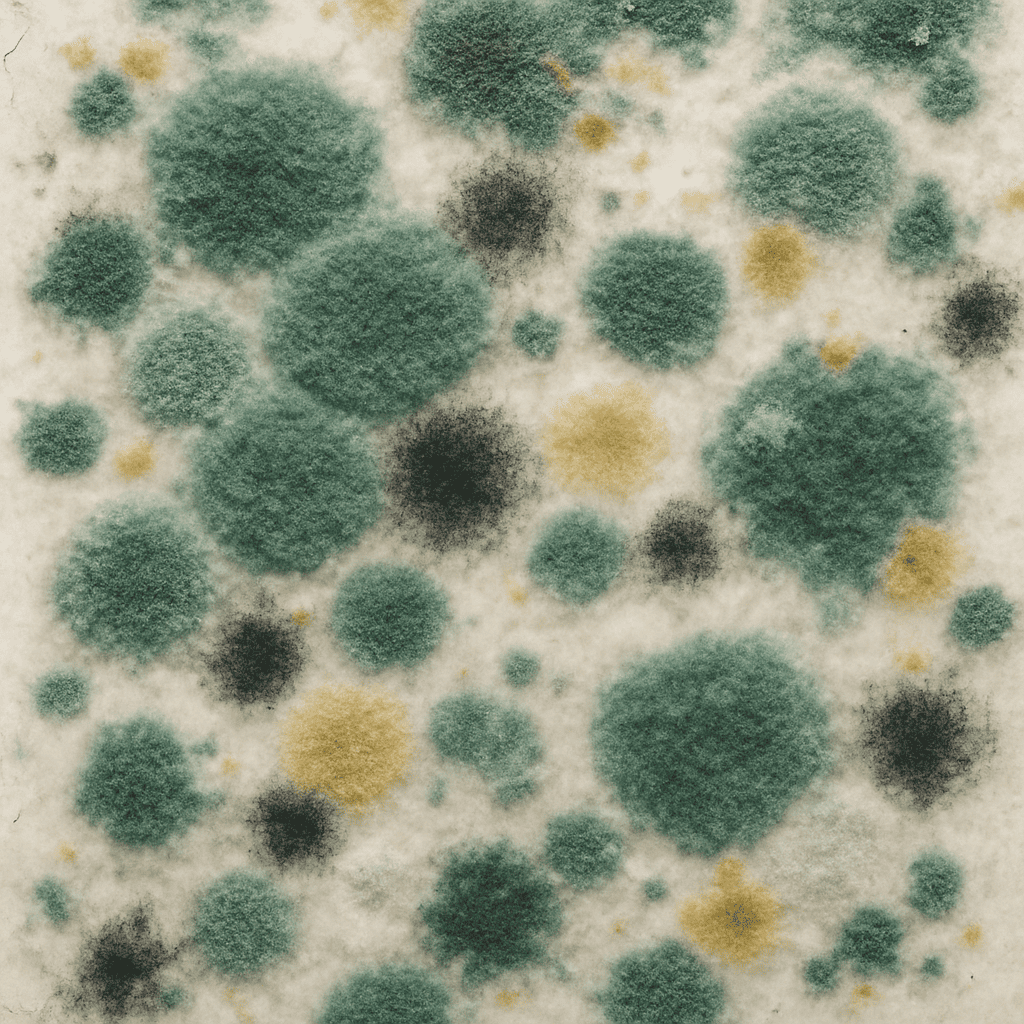
집 곰팡이가 위험한 이유

티스토리 뷰
목차
장마철이나 환기가 잘 안 되는 계절이 되면 어김없이 찾아오는 불청객, 곰팡이 때문에 고민이신가요? 😫 집 곰팡이는 단순한 미관상의 문제를 넘어 가족의 건강까지 위협하는 심각한 문제예요. 특히 알레르기나 호흡기 질환이 있는 분들에게는 더욱 신경 쓰이는 부분이죠. 오늘은 집 곰팡이를 완벽하게 제거하고 건강한 주거환경을 만드는 방법을 상세히 알려드릴게요!
📌 곰팡이로 인한 건강 문제가 걱정된다면? 곰팡이 알레르기 증상과 대처법에 대해 자세히 알아보세요.
🧐 집 곰팡이가 위험한 이유
곰팡이는 단순히 보기 싫은 것만이 아니라 실제로 건강에 여러 문제를 일으킬 수 있어요. 곰팡이 포자는 공기 중에 떠다니며 호흡기를 통해 체내로 들어와 알레르기 반응, 기침, 재채기, 두통 등을 유발할 수 있답니다. 특히 면역력이 약한 어린이나 노약자, 천식 환자에게는 더 심각한 영향을 미칠 수 있어요.
또한 곰팡이는 건물 구조에도 영향을 주어 벽지 손상, 목재 부식, 심지어 건물의 구조적 문제까지 일으킬 수 있어요. 그래서 발견 즉시 제대로 제거하는 것이 중요합니다.
🧹 집 곰팡이 완벽 제거법
1. 자연 친화적인 방법
화학 제품을 사용하기 전에 먼저 자연 친화적인 방법을 시도해 보세요. 안전하면서도 효과적이랍니다!
✅ 백식초와 물 혼합액: 백식초와 물을 1:1 비율로 섞어 스프레이 병에 담아 곰팡이가 핀 부분에 뿌리고 30분 정도 후에 닦아내세요. 식초의 산성 성분이 곰팡이를 제거하는 데 효과적이에요.
✅ 베이킹소다 활용법: 베이킹소다 2큰술과 물 1컵, 식초 1큰술을 섞어 곰팡이 부분에 바르고 1시간 후에 칫솔이나 수세미로 문질러 닦아내세요. 베이킹소다는 곰팡이 냄새 제거에도 탁월해요.
✅ 티트리 오일: 물 1컵에 티트리 오일 10방울을 섞어 스프레이로 뿌리면 곰팡이 제거와 예방에 도움이 됩니다. 자연 항균 효과가 있어 안전하게 사용할 수 있어요.

2. 전문 곰팡이 제거제 사용법
자연 친화적인 방법으로 제거되지 않는 심한 곰팡이는 전문 제거제를 사용해야 할 수도 있어요. 하지만 사용 시 반드시 장갑과 마스크를 착용하고, 창문을 열어 충분히 환기시키면서 사용하세요.
⚠️ 주의사항: 염소 계열 곰팡이 제거제(예: 락스)와 식초를 절대 함께 사용하지 마세요! 유독 가스가 발생할 수 있어 매우 위험합니다.
전문 곰팡이 제거제를 사용할 때는 제품 설명서를 꼼꼼히 읽고 지시에 따라 사용하세요. 보통은 제거제를 뿌리고 10~30분 정도 기다린 후 물로 깨끗이 씻어내는 방식이에요.
3. 부위별 곰팡이 제거 방법
🚿 욕실 곰팡이 제거
욕실은 습기가 많아 곰팡이가 가장 잘 생기는 장소예요. 타일 사이 줄눈에 생긴 곰팡이는 오래된 칫솔에 베이킹소다 페이스트를 묻혀 문질러 닦는 것이 효과적이에요. 실리콘 부분의 곰팡이는 미백 치약을 바르고 몇 시간 방치 후 닦아내면 효과적이랍니다.
🧱 벽지 곰팡이 제거
벽지에 생긴 곰팡이는 조심스럽게 다뤄야 해요. 젖은 천으로 가볍게 두드려 닦되, 너무 세게 문지르면 벽지가 손상될 수 있으니 주의하세요. 곰팡이가 심한 경우에는 전문가의 도움을 받아 벽지를 교체하는 것이 좋아요.
🪑 가구 및 직물 곰팡이 제거
나무 가구에 생긴 곰팡이는 부드러운 천에 식초와 물을 1:1로 섞은 용액을 묻혀 가볍게 닦아주세요. 그 후 마른 천으로 물기를 완전히 제거해야 해요. 소파나 매트리스 같은 직물에 생긴 곰팡이는 전문 세탁소를 찾는 것이 좋아요.


🛡️ 곰팡이 예방법: 재발 방지를 위한 습관
1. 습도 관리하기
곰팡이 예방의 가장 기본은 습도 관리예요. 실내 습도는 40~60% 사이로 유지하는 것이 이상적이에요. 제습기 사용, 환기 자주 하기, 빨래는 가능한 실외에서 말리기 등의 습관이 도움이 됩니다.
2. 정기적인 청소와 환기
일주일에 한 번은 집 안 구석구석을 청소하고, 하루에 최소 두 번(아침, 저녁) 10분 이상 환기시켜 주세요. 특히 욕실은 사용 후 반드시 문을 열어 습기가 빠져나가도록 해주는 것이 중요해요.
3. 누수 문제 즉시 해결
집 안에 누수가 발생했다면 곰팡이 번식의 주요 원인이 될 수 있어요. 천장이나 벽에 물 얼룩이 보이면 즉시 원인을 찾아 수리해야 해요. 방치하면 곰팡이 문제가 더 심각해질 수 있습니다.
4. 방습 제품 활용하기
옷장이나 신발장처럼 환기가 잘 안 되는 곳에는 습기제거제나 방습제를 두면 좋아요. 작은 투자로 큰 효과를 볼 수 있답니다.



❓ 집 곰팡이 관련 자주 묻는 질문
Q1: 곰팡이 제거 후에도 검은 자국이 남아있어요. 어떻게 해야 하나요?
A1: 곰팡이 자체는 제거되었지만 색소가 남은 경우일 수 있어요. 베이킹소다와 과산화수소를 1:2 비율로 섞어 페이스트를 만들어 자국에 바르고 말린 후 닦아내 보세요. 그래도 안 되면 페인트나 벽지 교체가 필요할 수 있어요.
Q2: 아이가 있는 집에서 안전하게 곰팡이를 제거하는 방법은 무엇인가요?
A2: 아이가 있는 가정에서는 화학 제품보다 식초, 베이킹소다 같은 자연 친화적인 방법을 먼저 시도해보세요. 전문 제품을 사용해야 할 경우, 아이를 다른 공간에 머무르게 하고 작업 후 충분히 환기시킨 뒤에 아이가 돌아오게 하는 것이 좋아요.
Q3: 옷이나 신발에 생긴 곰팡이는 어떻게 제거하나요?
A3: 옷은 식초를 물에 1:3 비율로 섞은 용액에 30분 정도 담근 후 세탁하면 효과적이에요. 신발은 이소프로필 알코올을 면봉에 묻혀 곰팡이 부분을 닦아낸 후 햇빛에 완전히 말려주세요. 가죽 제품은 전문 클리닝을 추천드려요.
Q4: 집 곰팡이 때문에 병원에 가야 할 상황은 언제인가요?
A4: 곰팡이 노출 후 호흡 곤란, 지속적인 기침, 두통, 발열, 피부 발진 등의 증상이 나타나면 즉시 의사와 상담하세요. 특히 면역력이 약한 사람, 알레르기나 천식이 있는 사람은 더 주의해야 해요.
Q5: 전문 곰팡이 제거 업체는 언제 부르는 것이 좋을까요?
A5: 곰팡이 면적이 1제곱미터 이상으로 넓거나, 여러 번 제거를 시도해도 계속 재발하는 경우, 특히 건물 구조에 영향을 줄 것으로 의심되는 경우에는 전문가의 도움을 받는 것이 좋아요. 전문가들은 원인 파악부터 근본적인 해결책까지 제시해 줄 수 있답니다.




🌱 마무리: 건강한 주거환경을 위한 작은 실천
곰팡이 없는 건강한 집을 만드는 것은 결코 어려운 일이 아니에요. 정기적인 청소와 환기, 습도 관리만으로도 대부분의 곰팡이 문제를 예방할 수 있답니다. 이미 곰팡이가 생겼다면 오늘 알려드린 방법으로 안전하게 제거하고, 앞으로는 예방 습관을 들여보세요.
여러분의 집이 곰팡이 없는 건강한 공간이 되길 바라요! 이 글이 도움이 되셨다면 주변 분들에게도 공유해 주세요. 😊
이전 글 목록
'일상생활 꿀팁' 카테고리의 다른 글
| 중고차 구매 시 꼭 확인해야 할 체크리스트 2025년 완벽 정리 (0) | 2025.05.21 |
|---|---|
| 전기차 배터리 수명 연장하는 충전 및 관리 꿀팁 총정리 | 더 오래 더 효율적으로 (0) | 2025.05.21 |
| 장마철 빨래 빨리 말리는 방법: 실내에서도 뽀송뽀송하게 해결하세요 (0) | 2025.05.20 |
| 2025년 재활용 분리배출 제대로 하는 방법 총정리 (0) | 2025.05.13 |
| 자동차 경고등 완벽 가이드: 2025년 안전 운전을 위한 필수 해석 및 대처법 (0) | 2025.05.09 |